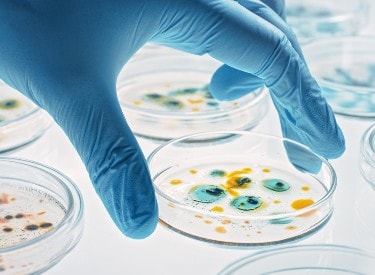

什么是无菌医疗器械?
无菌医疗器械是指产品不含活的细菌或其他微生物及其孢子。无菌医疗器械的要求由国家或地区的标准和法规确定,其中详细规定了无菌保证水平。医疗器械的灭菌包括:在规定条件下的环氧乙烷、伽马辐照、蒸汽、干热或化学灭菌,以及去除副产品所需的任何必要的后处理。




作为无菌医疗器械制造商,您必须确保产品在上市前符合相关法规要求。
欧盟公告机构、英国授权机构或审核机构的选择很重要,它们需要了解该行业并拥有丰富的经验进行评审及确认您的产品是否已具备上市的条件。
欧盟公告机构 - BSI 荷兰 (2797) – 依据欧盟医疗器械法规进行符合性评审。
英国授权机构 - BSI 英国 (0086) -依据英国医疗器械法规进行符合性评审。
BSI Group America Inc. -是公认的审核机构。
对于医疗器械制造商来说,将符合要求的产品高效、安全地上市可能极具挑战。我们提供标准(standard)和专属(dedicated)产品评审服务,助力产品高效上市。

医疗器械灭菌是一个专业过程,需要特定的知识和专业技能。BSI微生物团队专家拥有平均超过 20 年的微生物学经验,全球 90% 以上的灭菌站选择BSI作为认证机构。
BSI微生物技术专家熟知各类灭菌方法,凭借其专业积淀,可对所有领域的受控环境和医疗器械无菌性进行专业评估,包括牙科、眼科、骨科、心血管、有源植入、有源、带药、动物源和通用无菌器械。